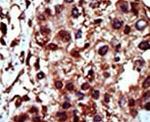
DGKI Antibody in Immunohistochemistry (IHC)

Search
Invitrogen
DGKI Polyclonal Antibody
{{$productOrderCtrl.translations['antibody.pdp.commerceCard.promotion.promotions']}}
{{$productOrderCtrl.translations['antibody.pdp.commerceCard.promotion.viewpromo']}}
{{$productOrderCtrl.translations['antibody.pdp.commerceCard.promotion.promocode']}}: {{promo.promoCode}} {{promo.promoTitle}} {{promo.promoDescription}}. {{$productOrderCtrl.translations['antibody.pdp.commerceCard.promotion.learnmore']}}
产品信息
PA5-15408
宿主/亚型
分类
类型
抗原
偶联物
形式
浓度
保存条件
运输条件
RRID
靶标信息
Diacylglycerol (DAG) influences numerous cell signaling cascades by functioning as an intracellular, allosteric activator of protein kinase C (PKC), and as a potent activator of guanine nucleotide exchange factors. In order to maintain cellular homeostasis, intracellular DAG levels are tightly regulated by diacylglycerol kinases (DGKs, DAGKs), which phosphorylate DAG to phosphatidic acid, thus removing DAG. Human DGK-α (80 kDa), -β (90 kDa), and - γ (90 kDa) have calcium-binding EF-hand motifs at their N termini and are classified as type I DGKs. Human DGK-δ (130 kDa) and DGK-ι (130 kDa) contain N-terminal pleckstrin homology (PH) domains and are classified as type II. Human DGK-epsilon (64 kDa) contains no identifiable regulatory domains and is classified as a type III DGK. Human DGK-Ω (104 kDa) and -iota (130 kDa) possess C-terminal ankyrin repeats and are classified as type IV DGKs. Human DGK-θ (110 kDa) contains 3 cysteine-rich domains and a PH domain and is classified as a type V DGK.
仅用于科研。不用于诊断过程。未经明确授权不得转售。